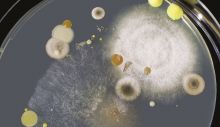

БАКТЕРИЈА
ОПРЕЗ! Смртоносна бактерија у вашем дому увек се налази на истом месту
Бактерије се могу наћи на различитим емстима у вашем дому, али одвод је најопасније место.